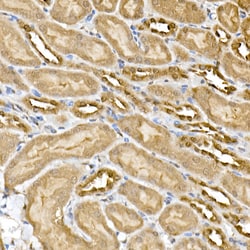
Invitrogen ERK1/ERK2 Recombinant Rabbit Monoclonal Antibody (9H6G8) 100

missing translation for 'onlineSavingsMsg'
Learn More
Learn More
Invitrogen™ ERK1/ERK2 Recombinant Rabbit Monoclonal Antibody (9H6G8)


Rabbit Recombinant Monoclonal Antibody
Brand: Invitrogen™ MA551411
This item is not returnable.
View return policy
Description
Immunogen sequence: FLTEYVATRW YRAPEIMLNS KGYTKSIDIW SVGCILAEML SNRPIFPGKH YLDQLNHILG ILGSPSQEDL NCIINMKARN YLQSLPSKTK VAWAKLFPKS D/LNSKGYTK SIDIWSVGCI LAEMLSNRPI FPGKHYLDQL NHILGILGSP SQEDLNCIIN LKARNYLLSL PHKNKVPWNR LFPNADSKAL DLLDKMLTFN PHK.
ERK1 and ERK2 are widely expressed and are involved in the regulation of meiosis, mitosis, and postmitotic functions in differentiated cells. Many different stimuli, including growth factors, cytokines, virus infection, ligands for heterotrimeric guanine nucleotide-binding protein (G protein)-coupled receptors and transforming agents, activate the ERK1 and ERK2 pathways. When growth factors bind to the receptor tyrosine kinase, Ras interacts with Raf, the serine/threonine protein kinase and activates it as well. Once actived, Raf phosphorylates serine residue in 2 further kinases, MEK1/2, which in turn phosphorylates tyrosine/threonine in extracellular-signal regulated kinase (ERK) 1/2. Upon activation, the ERKs either phosphorylate a number of cytoplasmic targets or migrate to the nucleus, where they phosphorylate and activate a number of transcription factors such as c-Fos and Elk-1.
Specifications
| ERK1/ERK2 | |
| Recombinant Monoclonal | |
| 1 mg/mL | |
| PBS with 0.05% BSA, 50% glycerol and 0.05% ProClin 300; pH 7.3 | |
| P21708, P27361, P28482, P63085, P63086, Q63844 | |
| MAPK1, MAPK3 | |
| A synthetic peptide corresponding to a sequence within amino acids 200-300 of human ERK1/2ERK1/2 (NP_002737.2/NP_002736.3). | |
| 100 μL | |
| Primary | |
| Human, Mouse, Rat | |
| Antibody | |
| Liquid |
| ELISA, Immunohistochemistry (Paraffin), Western Blot | |
| 9H6G8 | |
| Unconjugated | |
| MAPK1 | |
| 12559; 9030612K14Rik; AA407128; AU018647; BcDNA:RE08694; C78273; CG12559; CG12559-PA; CG12559-PC; CG12559-PD; CG12559-PE; CG12559-PG; CG12559-PH; CG12559-PI; CG18732; CT34260; CT39192; DERK; D-ERK; DERK-A; Diphospho-ERK; dm-dpERK; Dmel\CG12559; Dmel_CG12559; DmErk; DmERKA; DmERK-A; DmMAPK; dpERK; dp-ERK; dpERK1; dpMAPK; drosophila ERK; Dsor2; E(sina)7; EC2-1; EK2-1; enhancer of seven in absentia 7; ERK; Erk MAP kinase; Erk/Map kinase; ERK/rolled; Erk1; Erk-1; erk1 erk2; Erk1/2; ERK1b; ERK2; ERK-2; ERKA; ERK-A; ERT1; ERT2; Esrk1; extracellular signal-regulated kinase; extracellular signal-regulated kinase (ERK2); extracellular signal-regulated kinase 1; Extracellular signal-regulated kinase 2; extracellular signal-regulated kinase A; extracellular signal-regulated kinase-1; extracellular signal-regulated kinase-2; extracellular signal-related kinase 1; Extracellular-regulated kinase A; extracellular-signal-regulated kinase 2; Extracellular-signal-related kinase A; EY2-2; fi06b09; GroupII; HS44KDAP; HUMKER1A; I79_009500; I79_018350; insulin-stimulated MAP2 kinase; l(2)41Ac; l(2R)EMS45-39; M phase MAP kinase; MAP kinase; MAP kinase 1; MAP kinase 2; MAP kinase 3; MAP kinase isoform p42; MAP kinase isoform p44; MapK; MAP-k; MAPK 1; MAPK 2; MAPK 3; MAPK1; mapk1.S; mapk1a; mapk1-a; mapk1-b; mapk2; mapk3; MAP-kinase; MBP kinase; Microtubule-associated protein 2 kinase; mitogen activated protein kinase; mitogen activated protein kinase 1; mitogen activated protein kinase 3; mitogen-activated 3; mitogen-activated protein kinase; mitogen-activated protein kinase 1; mitogen-activated protein kinase 1 S homeolog; mitogen-activated protein kinase 1a; mitogen-activated protein kinase 2; Mitogen-activated protein kinase 3; Mitogen-activated protein kinase ERK-A; MNK1; mpk1; Mtap2k; Myelin basic protein kinase; Myelin xP42 protein kinase; p38; p40; p41; p41mapk; p42; p42 MAP Kinase; P42MAPK; p42-MAPK; p44; p44 MAP kinase; p44erk1; p44-ERK1; p44mapk; p44-MAPK; pERK; p-ERK; phospho-ERK; pMapK; pp42/MAP kinase; Prkm1; PRKM2; Prkm3; protein kinase; Protein rolled; protein tyrosine kinase ERK2; RE08694p; RL; rl/ERK; rl/MAPK; rll; rl-PA; rl-PC; rl-PD; rl-PE; rl-PG; rl-PH; rl-PI; roll; rolled; sem; sevenmaker; SR2-1; Su(Raf)2B; wu:fi06b09; XELAEV_18010534mg; xp42; zERK1; zERK2 | |
| Rabbit | |
| Affinity Chromatography | |
| RUO | |
| 116590, 26413, 26417, 50689, 5594, 5595 | |
| -20°C, Avoid Freeze/Thaw Cycles | |
| Liquid | |
| IgG |
Product Content Correction
Your input is important to us. Please complete this form to provide feedback related to the content on this product.
Product Title
Spot an opportunity for improvement?Share a Content Correction